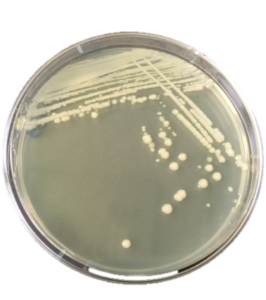

ชื่อวิทยาศาสตร์ : Bacillus subtilis.

ประโยชน์ : ใช้ในการป้องกันและควบคุมโรคพืชที่เกิดจากเชื้อรา และแบคทีเรียหลายชนิด เช่น
คุณสมบัติของเชื้อบีเอส
- เป็นเชื้อจุลินทรีย์ที่โดยปกติมักจะพบอาศัยอยู่ภายในพืชโดยไม่ก่อให้เกิดผลเสียหายต่อพืชที่อาศัยอยู่
- สามารถเข้าทำลายโดยตรงทั้งยังสามารถสร้างสารปฏิชีวนะได้หลายชนิด และสามารถแก่งแย่งธาตุอาหาร
- ได้ดีกว่าจุลินทรีย์อื่น ๆ ในสภาพแวดล้อมที่ขาดแคลน
- มีความสามารถในการปรับตัวและทนทานต่อสภาพแวดล้อมที่แปรเปลี่ยน และวิกฤต โดยการสร้างสปอร์
- และทนต่อสภาพอากาศร้อนชื้นได้ดี
- ส่งเสริมความต้านทาน ควบคุมโรคพืชที่มีสาเหตุจากเชื้อแบคทีเรียและเชื้อราโรคพืช
- กระตุ้นความงอกและส่งเสริมความแข็งแรงของพืช
- ย่อยสลายสารเคมีป้องกันกำจัดศัตรูพืชตกค้างในดิน
————————————————
เตรียมอุปกรณ์
- ถังพลาสติกสีดำ ขนาด 40 ลิตร
- ทำการเจาะรู นำสายออกซิเจนความยาว 1 เมตร สอดเข้าเข้าไปในรูที่เจาะไว้
- ติดหัวทรายขนาด 2.5 เซนติเมตร ที่บริเวณปลายสายออกซิเจนด้านในถัง
- ให้ออกซิเจนด้วยปั๊มอากาศขนาดเล็ก กำลังไฟ 3 วัตต์
————————————————–
วิธีเพาะเลี้ยงเชื้อ

- เติมน้ำสะอาด (น้ำถัง/กรอง) หรือน้ำสุกอุ่น ปริมาตร 20 ลิตร
- ใส่หัวเชื้อ และอาหาร (ยีสหวาน ที่ฆ่าเชื้อแล้ว) ปิดฝา เปิดปั๊มให้อากาศ
- รอประมาณ 24 ชั่วโมง นำไปใช้ได้
————————————————–
วิธีและอัตราการใช้
- กระตุ้นความงอก และส่งเสริมความแข็งแรงของพืช โดยคลุกเมล็ด อัตรา 10 -100 มิลลิลิตรต่อเมล็ด 1 กิโลกรัม
- ส่งเสริมความต้านทานโรคและควบคุมโรคพืช เช่น พริก ข้าว ข้าวโพดพืชผักตระกูลกะหล่ำ เป็นต้น พ่นลงบนต้นพืช อัตรา 100 – 1000 มิลลิลิตรต่อน้ำ 20 ลิตร พ่นทุก ๆ 7 – 15 วัน
** ควรใช้ในช่วงเวลาเย็น และควรใช้ให้หมดหลังหมักขยายแล้วไม่เกิน 7 วัน
- ที่มา : วิลาวรรณ์ เชื้อบุญ
- เรียบเรียง : ภัควรินทร์ พัฒนมณีศักดิ์